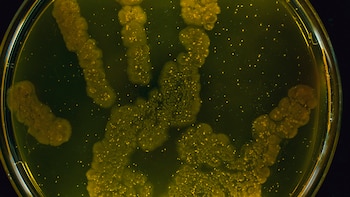
Para este 5 de mayo, la OPS impulsa la jornada bajo el lema: “Juntos, podemos acelerar la acción para prevenir infecciones y resistencia a los antimicrobianos en la atención de la salud y construir una cultura de seguridad y calidad en la cual a la mejora de la higiene de las manos se le da alta prioridad" / (Getty Images)

Uno de los hábitos que los médicos y personal sanitario ha promovido y aún lo hace en el mundo, especialmente después de la pandemia por COVID-19, es el correcto y permanente lavado o higiene de manos, ya que es una parte esencial de una cultura de autocuidado y prevención de varias enfermedades. En el mundo, hay dos fechas en las que se promueve el lavado de manos bajo el nombre de Día Mundial de la Higiene de Manos. Se trata del 5 de mayo y el 15 de octubre. Sin embargo, sin importar el calendario, esta simple acción cambió, incluso, a la humanidad.
El lavado de manos salva vidas, es la medida más económica, sencilla y eficaz para reducir el riesgo de infecciones y hace parte de las recomendaciones en la lucha contra la resistencia antimicrobiana (RAM), una de las 10 principales amenazas para la salud pública a las que se enfrenta el mundo.
PUBLICIDAD
La ciencia, la investigación y los datos estadísticos respaldan esta medida. Las manos se convierten en vehículo y mecanismo de transmisión por contacto para diversos microorganismos. Por ejemplo, cuando una persona tiene gripe y tose puede ‘lanzar’ al ambiente hasta 3.000 gotas de secreciones y en ellas pueden estar diversos tipos de gérmenes, que pueden sobrevivir hasta 30 horas en superficies o fómites, dependiendo del material del que estén hechos y del tipo de microorganismo.

Es así como las manos han sido consideradas un mecanismo de transmisión de varios virus como el de influenza y COVID, entre otros, ya que cuando están sucias lo transportan a nariz, ojos o boca, y a partir de allí ingresa al cuerpo. Los seres humanos entramos en “contacto con el mundo” la mayor parte del tiempo a través de nuestras manos. A través de ellas se toca y se aprende; se escribe, se come, se juega; se da afecto; y se manipula todo tipo de objetos. Esto también las convierte en las principales portadoras de gérmenes, que pueden causar enfermedades.
PUBLICIDAD
Un hábito tan simple como el de lavarse las manos, puede ser la clave para salvar millones de vidas. Con el 5 de mayo como excusa y principal impulsor de esta acción, se hace un llamado a toda la población, además de personal de salud y otros actores esenciales, para concientizar acerca de la importancia de este comportamiento para prevenir enfermedades.
Según un estudio de la OPS, higienizarse las manos con agua y jabón reduce 50% las diarreas infantiles y 25% las infecciones respiratorias.

En diálogo con Infobae, el doctor Damián Zopatti, director de Estadística, Internaciones y Archivo Médico del Hospital de Clínicas José de San Martín (MN 111.505) explicó que “lavarse con agua y jabón es lo más efectivo para eliminar virus y bacterias de la superficie corporal, no hay un producto mejor, es tan sencillo como eso, el agua barre y va eliminando ciertas partículas y algunas bacterias, pero eso no es suficiente, es necesario el agregado de jabón o detergente que genere espuma”.
PUBLICIDAD
“Las manos humanas poseen millones de microbios provenientes de un sin número de fuentes como las heces, carnes, verduras, superficies, entre otros. Estos microbios llegan a nuestros ojos, nariz y boca cuando tocamos nuestro rostro e incluso se traspasan a través de superficies, propiciando el contagio con otras personas. Por lo tanto, eliminar los microbios mediante el lavado de manos ayuda a prevenir enfermedades como la diarrea y las infecciones respiratorias y podría incluso ayudar a prevenir infecciones en la piel y los ojos”, explicó Gerardo Laube, profesor titular de microbiología y de infectología de la Facultad de Medicina Fundación Barceló.
¿Cada cuánto hay que lavarse las manos?
Es importante entender que la higiene de manos no es una acción que deba volverse compulsiva, sino más bien un hábito que debe incorporarse a la rutina de cada persona de manera adecuada. La clave no es lavarse las manos cada dos segundos, sino hacerlo en los momentos indicados y de la manera correcta. Es por ello que Laube brindó una serie tips claves a la hora de lavarse las manos:
PUBLICIDAD

¿Cuándo debemos lavarnos las manos?
-Antes de comer y cocinar.
-Antes de amamantar.
-Después de ir al baño o cambiar pañales.
-Luego de sonarse la nariz, estornudar o toser.
-Luego de visitar a un enfermo.
-Al estar en contacto con los residuos.
-Al estar en contacto con animales.
-Después de tocar alimentos crudos y antes de tocar alimentos cocidos.
-Después de llegar del exterior a la casa.
Cuáles son los 5 pasos para realizar un correcto lavado de manos
El especialista explicó que para lograr una óptima higienización lo mejor es hacerlo con agua limpia, jabón y siguiendo estos pasos:
1 -Mojar las manos con agua corriente limpia y enjabonarse las manos.
2 -Frotar las manos con jabón hasta que haga espuma sobre el dorso, palma y entre los dedos.
3 -Refregar las manos en su totalidad durante, mínimo, 20 segundos.
4 -Enjuagar bien las manos con agua corriente limpia.
5 -Secar con una toalla limpia o al aire.

Los mitos más frecuentes del lavado de manos
-¿Tengo que abrir la canilla de agua hasta el punto más caliente?
No. Los Centros para el Control y la Prevención de Enfermedades (CDC, por sus siglas en inglés) de Estados Unidos, asegura que no es necesario lavarse las manos hasta quemarse la piel. Por eso, es necesario que utilices la temperatura adecuada pero, más que nada, usar jabón de manera correcta.
PUBLICIDAD
-¿Hay que usar jabón antibacterial?
No hace falta. Con un jabón de los clásicos alcanza. Cuando se lavan las manos hay que respetar tres áreas: el dorso, entre los dedos y debajo de las uñas. Y la duración del lavado de manos tiene que ser de al menos 20 segundos. También es muy importante el secado de manera adecuada porque hay menos chance que el virus se propague de manera en un entorno seco.
PUBLICIDAD
Asimismo, el alcohol en gel no reemplaza el lavado de manos con agua y con jabón. Pero en caso que la persona no pueda lavarse las manos, se puede recurrir al alcohol en gel y se tienen que tener en cuenta las mismas zonas que al lavar las manos.
Seguir leyendo:
PUBLICIDAD
PUBLICIDAD
Últimas Noticias
El azúcar oculto en los alimentos que parecen saludables: cómo reconocerlo
Expertos de Harvard y la Organización Mundial de la Salud advierten que el consumo promedio de esta sustancia casi duplica el límite recomendado, y que pequeños cambios en etiquetas y condimentos pueden marcar una diferencia real

Por qué las sardinas pueden ser aliadas del corazón, el cerebro y los huesos
Su perfil nutricional resalta por el aporte de proteínas, grasas saludables, vitaminas y minerales. Especialistas explican cómo elegirlas y en qué casos conviene moderar su consumo

Por qué más peso no siempre es mejor para el entrenamiento de fuerza
El auge del ejercicio de fuerza instaló la idea de que progresar es sinónimo de sumar kilos a la barra, pero los especialistas advierten que más peso no siempre es mejor. Cuál es la carga ideal y qué rol tiene la técnica para un entrenamiento seguro

Presbicia: por qué cuesta ver de cerca después de los 40 y cómo se corrige
Aunque suele aparecer de manera gradual, puede afectar la lectura, el trabajo frente a pantallas y otras actividades diarias. Cleveland Clinic explica cuáles son las señales más comunes y cuándo conviene consultar a un especialista

La generación de la resiliencia: qué hay detrás de la fortaleza de los nacidos en los años 60 y 70, según la psicología
Su infancia transcurrió con escasa supervisión adulta y mayores responsabilidades, condiciones que, según especialistas, promovieron la autonomía y la capacidad para afrontar dificultades




